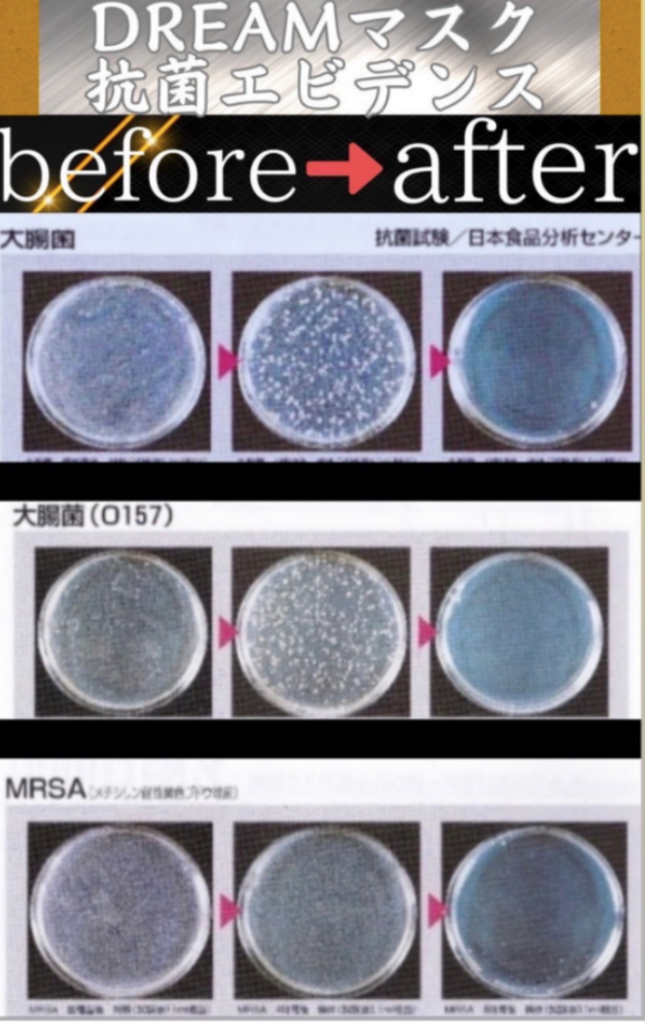

抗菌性作品シリーズ
–最高峰の抗菌技術を
駆使した作品たち–
抗菌性作品シリーズは、世界最高峰のランクで抗菌性試験をクリアした作品を提供しています。
私たちの作品は、日常生活で使用するあらゆるアイテムに、抗菌技術を施し、衛生面と健康面をサポートします。
さらに、作品に使用される吸汗速乾繊維と白金ナノ粒子により、快適さと免疫力向上が期待できます。

–抗菌性試験で証明された効果–
厳格な抗菌性試験をクリアし、エビデンスを取得している作品は、長期間使用しても抗菌性能が維持され、衛生的な生活をサポートします。
すべての作品は、免疫力向上に寄与する成分を使用し、体温を上げる効果も期待されています。
この作品の信頼性は、東久邇宮文化賞の受賞にも裏付けられています。
自衛隊にも採用された実績が、その高い品質を証明しています。

–快適さと効果を追求した
次世代ルームウェア–
超微細振動超抗菌パジャマと超微細振動靴下は、次世代の快適さと機能性を兼ね備えた作品です。
2024年11月3日には、東久邇宮文化賞を受賞し、『大衆のノーベル賞』とも称される名誉ある賞を受けました。
この受賞は、革新技術と高い品質を持つ製品として、社会から高く評価された証です。

–抗菌性作品で新しい生活を–
毎日使うアイテムが、あなたの健康を守ります。
抗菌シリーズは、科学的に証明された安全性と健康維持機能を提供し、日常生活の中で手軽に健康維持をサポートします。
安心して使える、抗菌機能付きの作品をぜひお試しください。
コメント
この記事へのコメントはありません。
この記事へのトラックバックはありません。